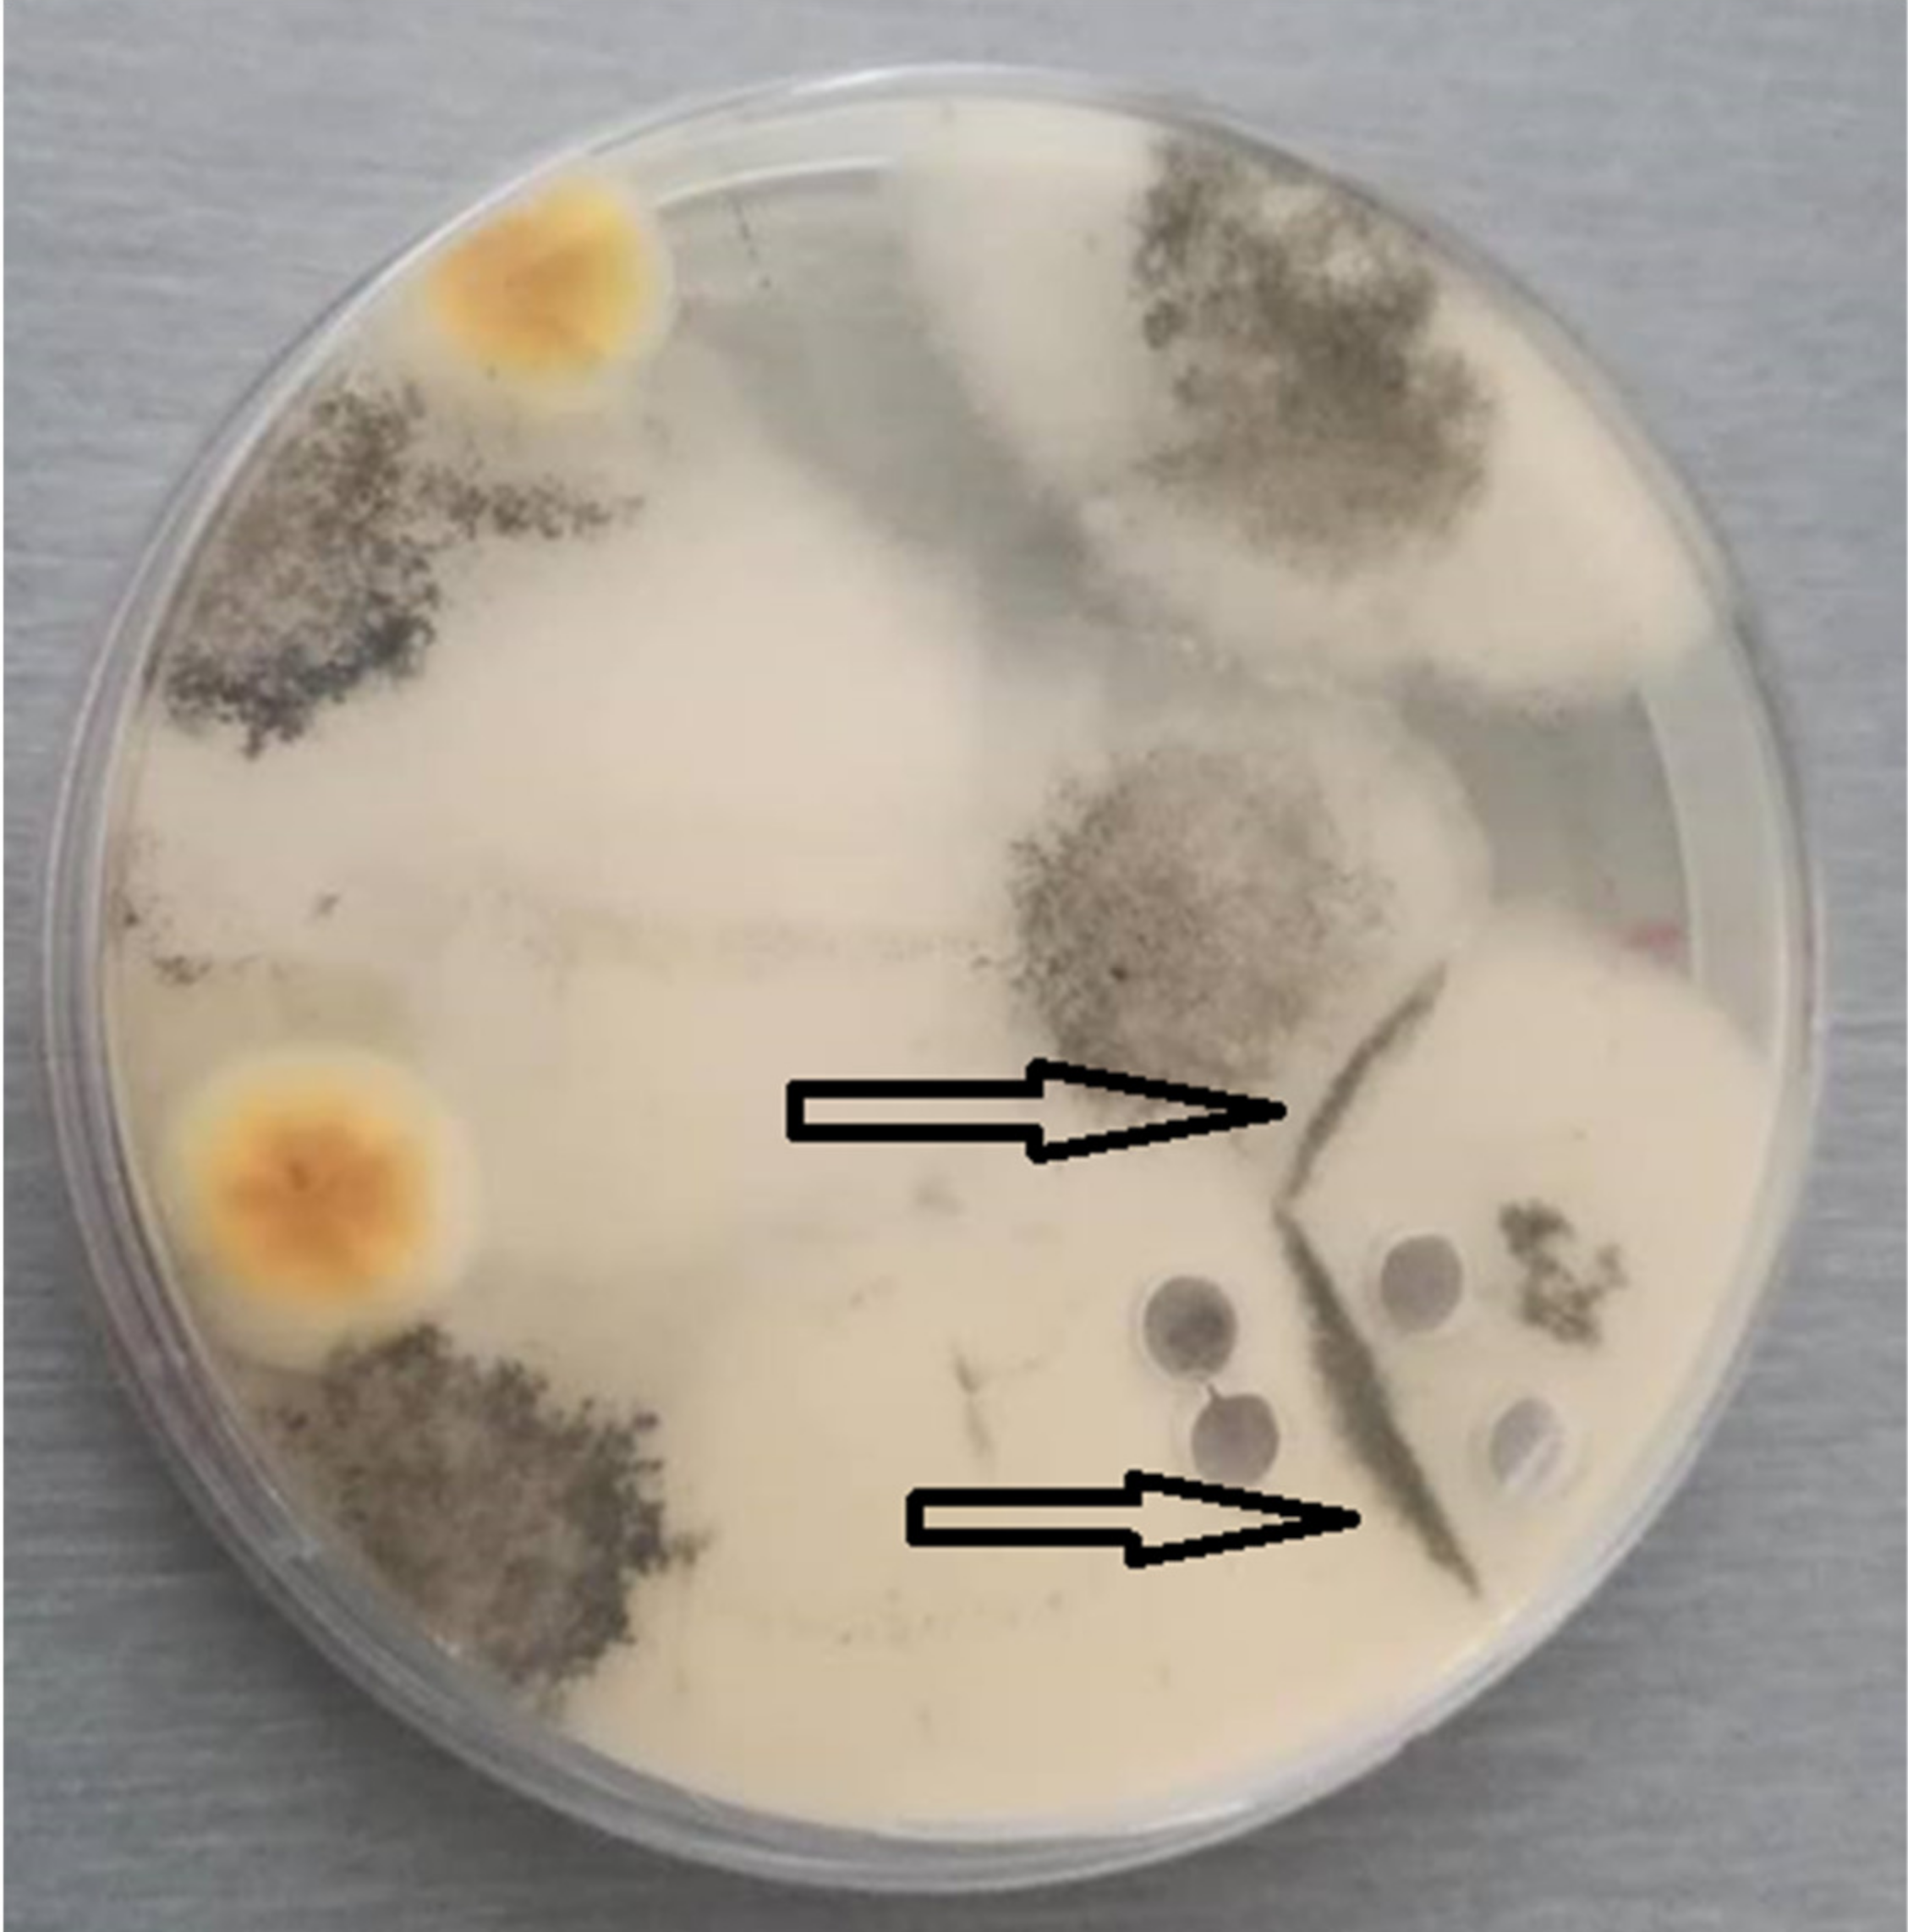
Biology 10 00431 g002
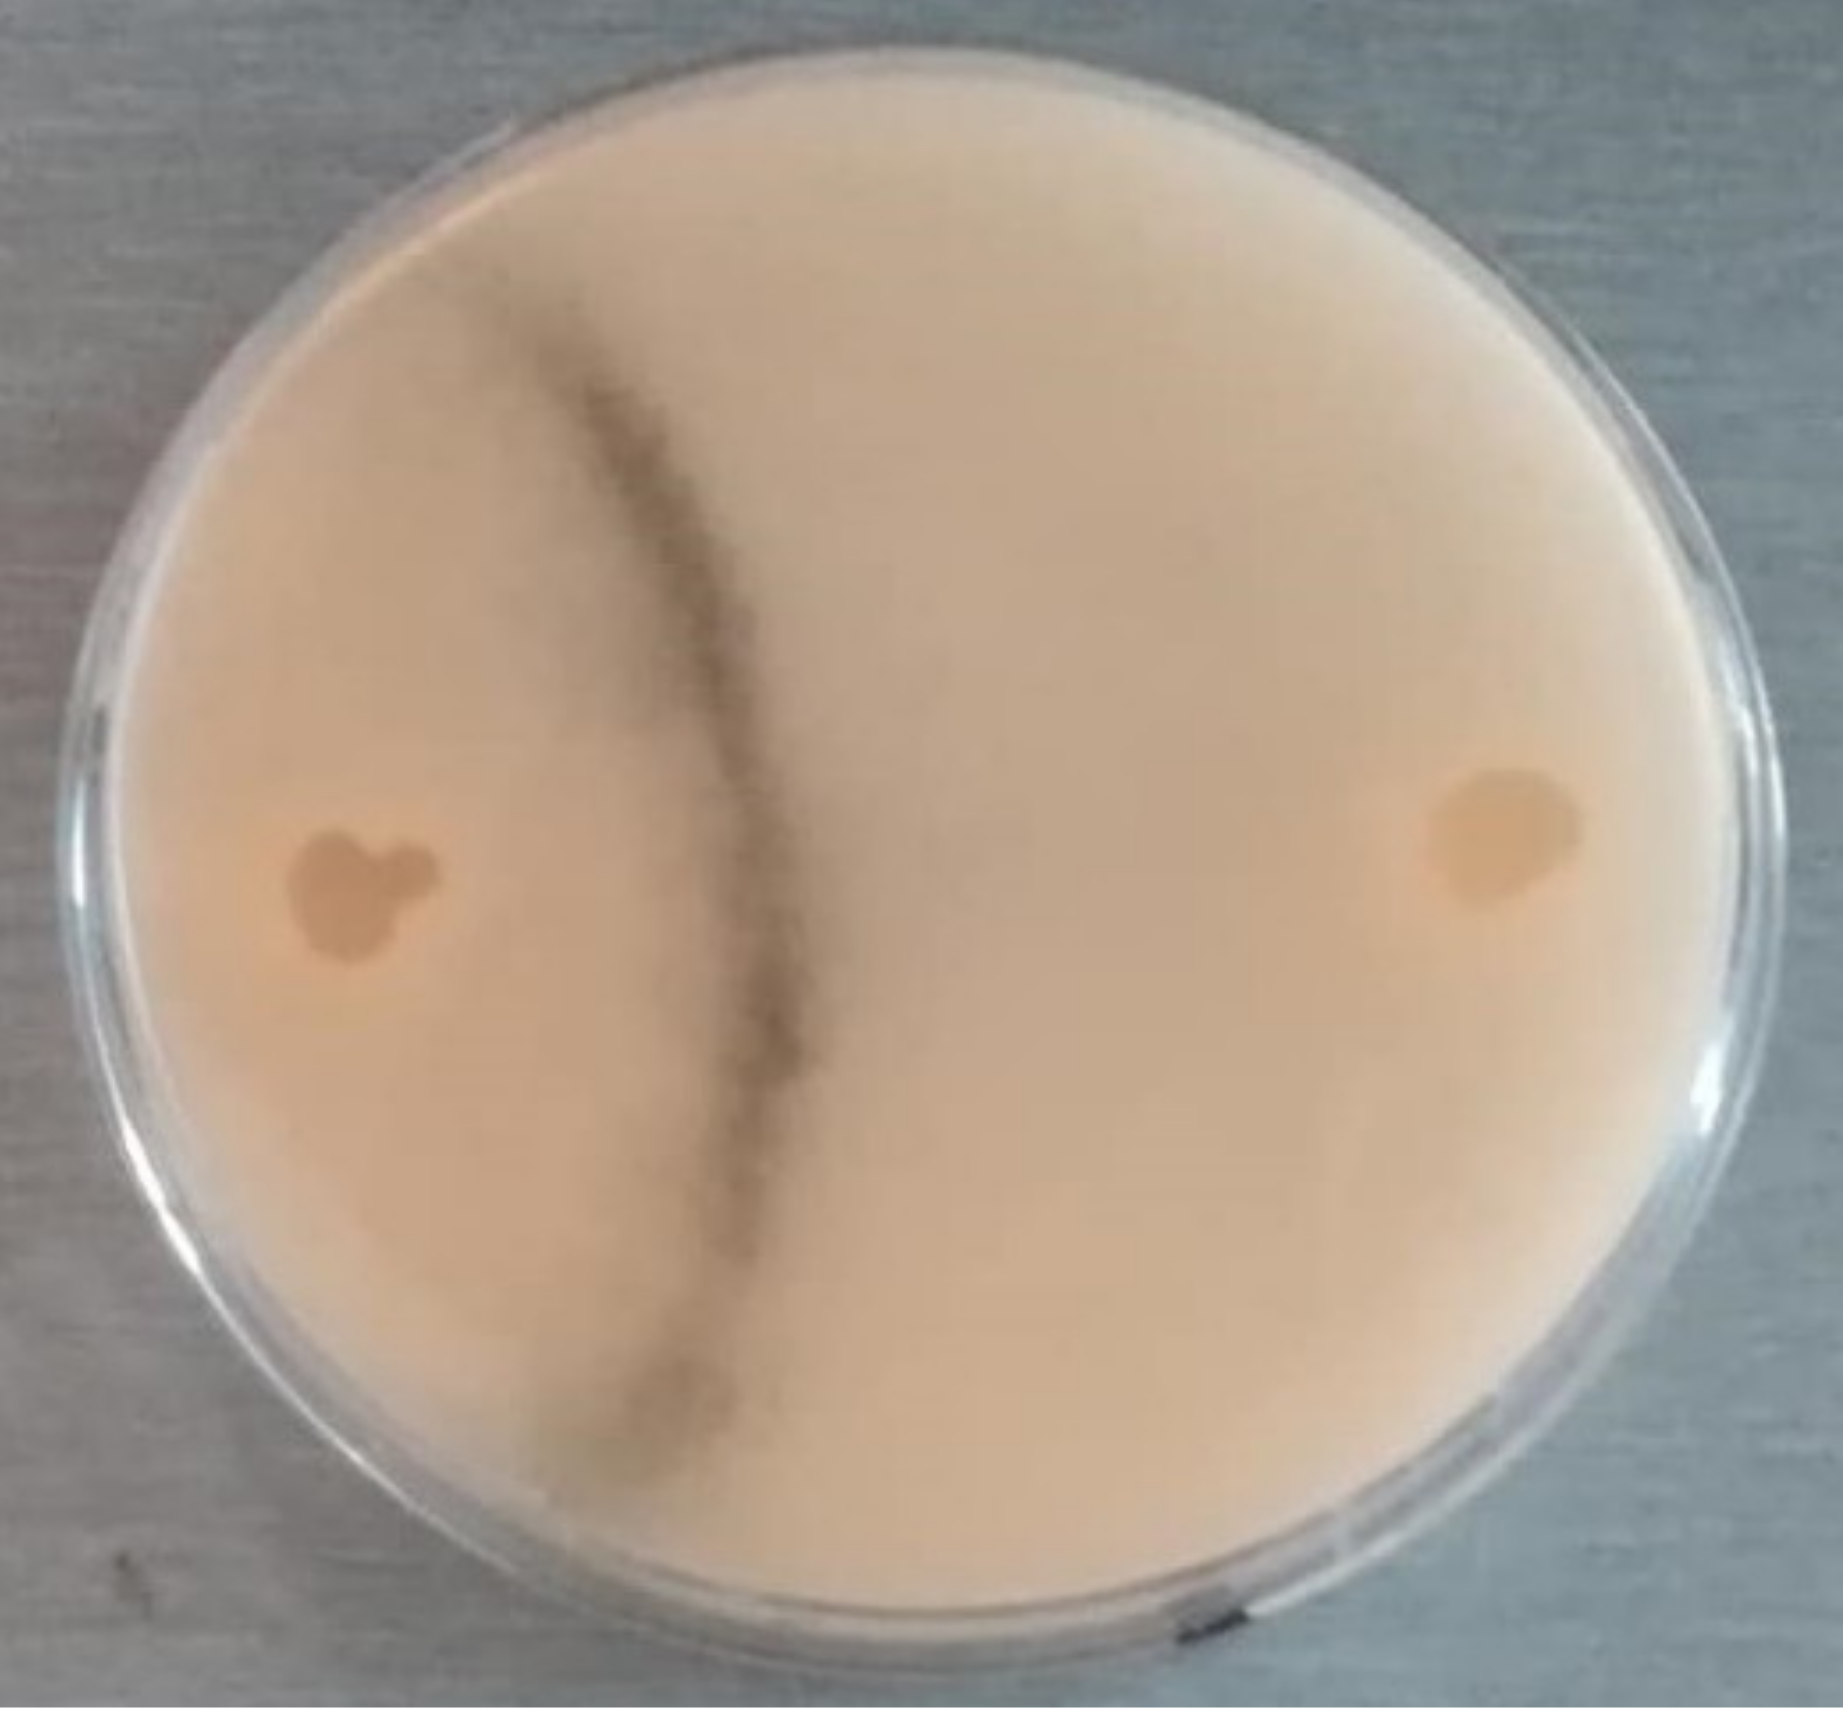
Biology 10 00431 g003
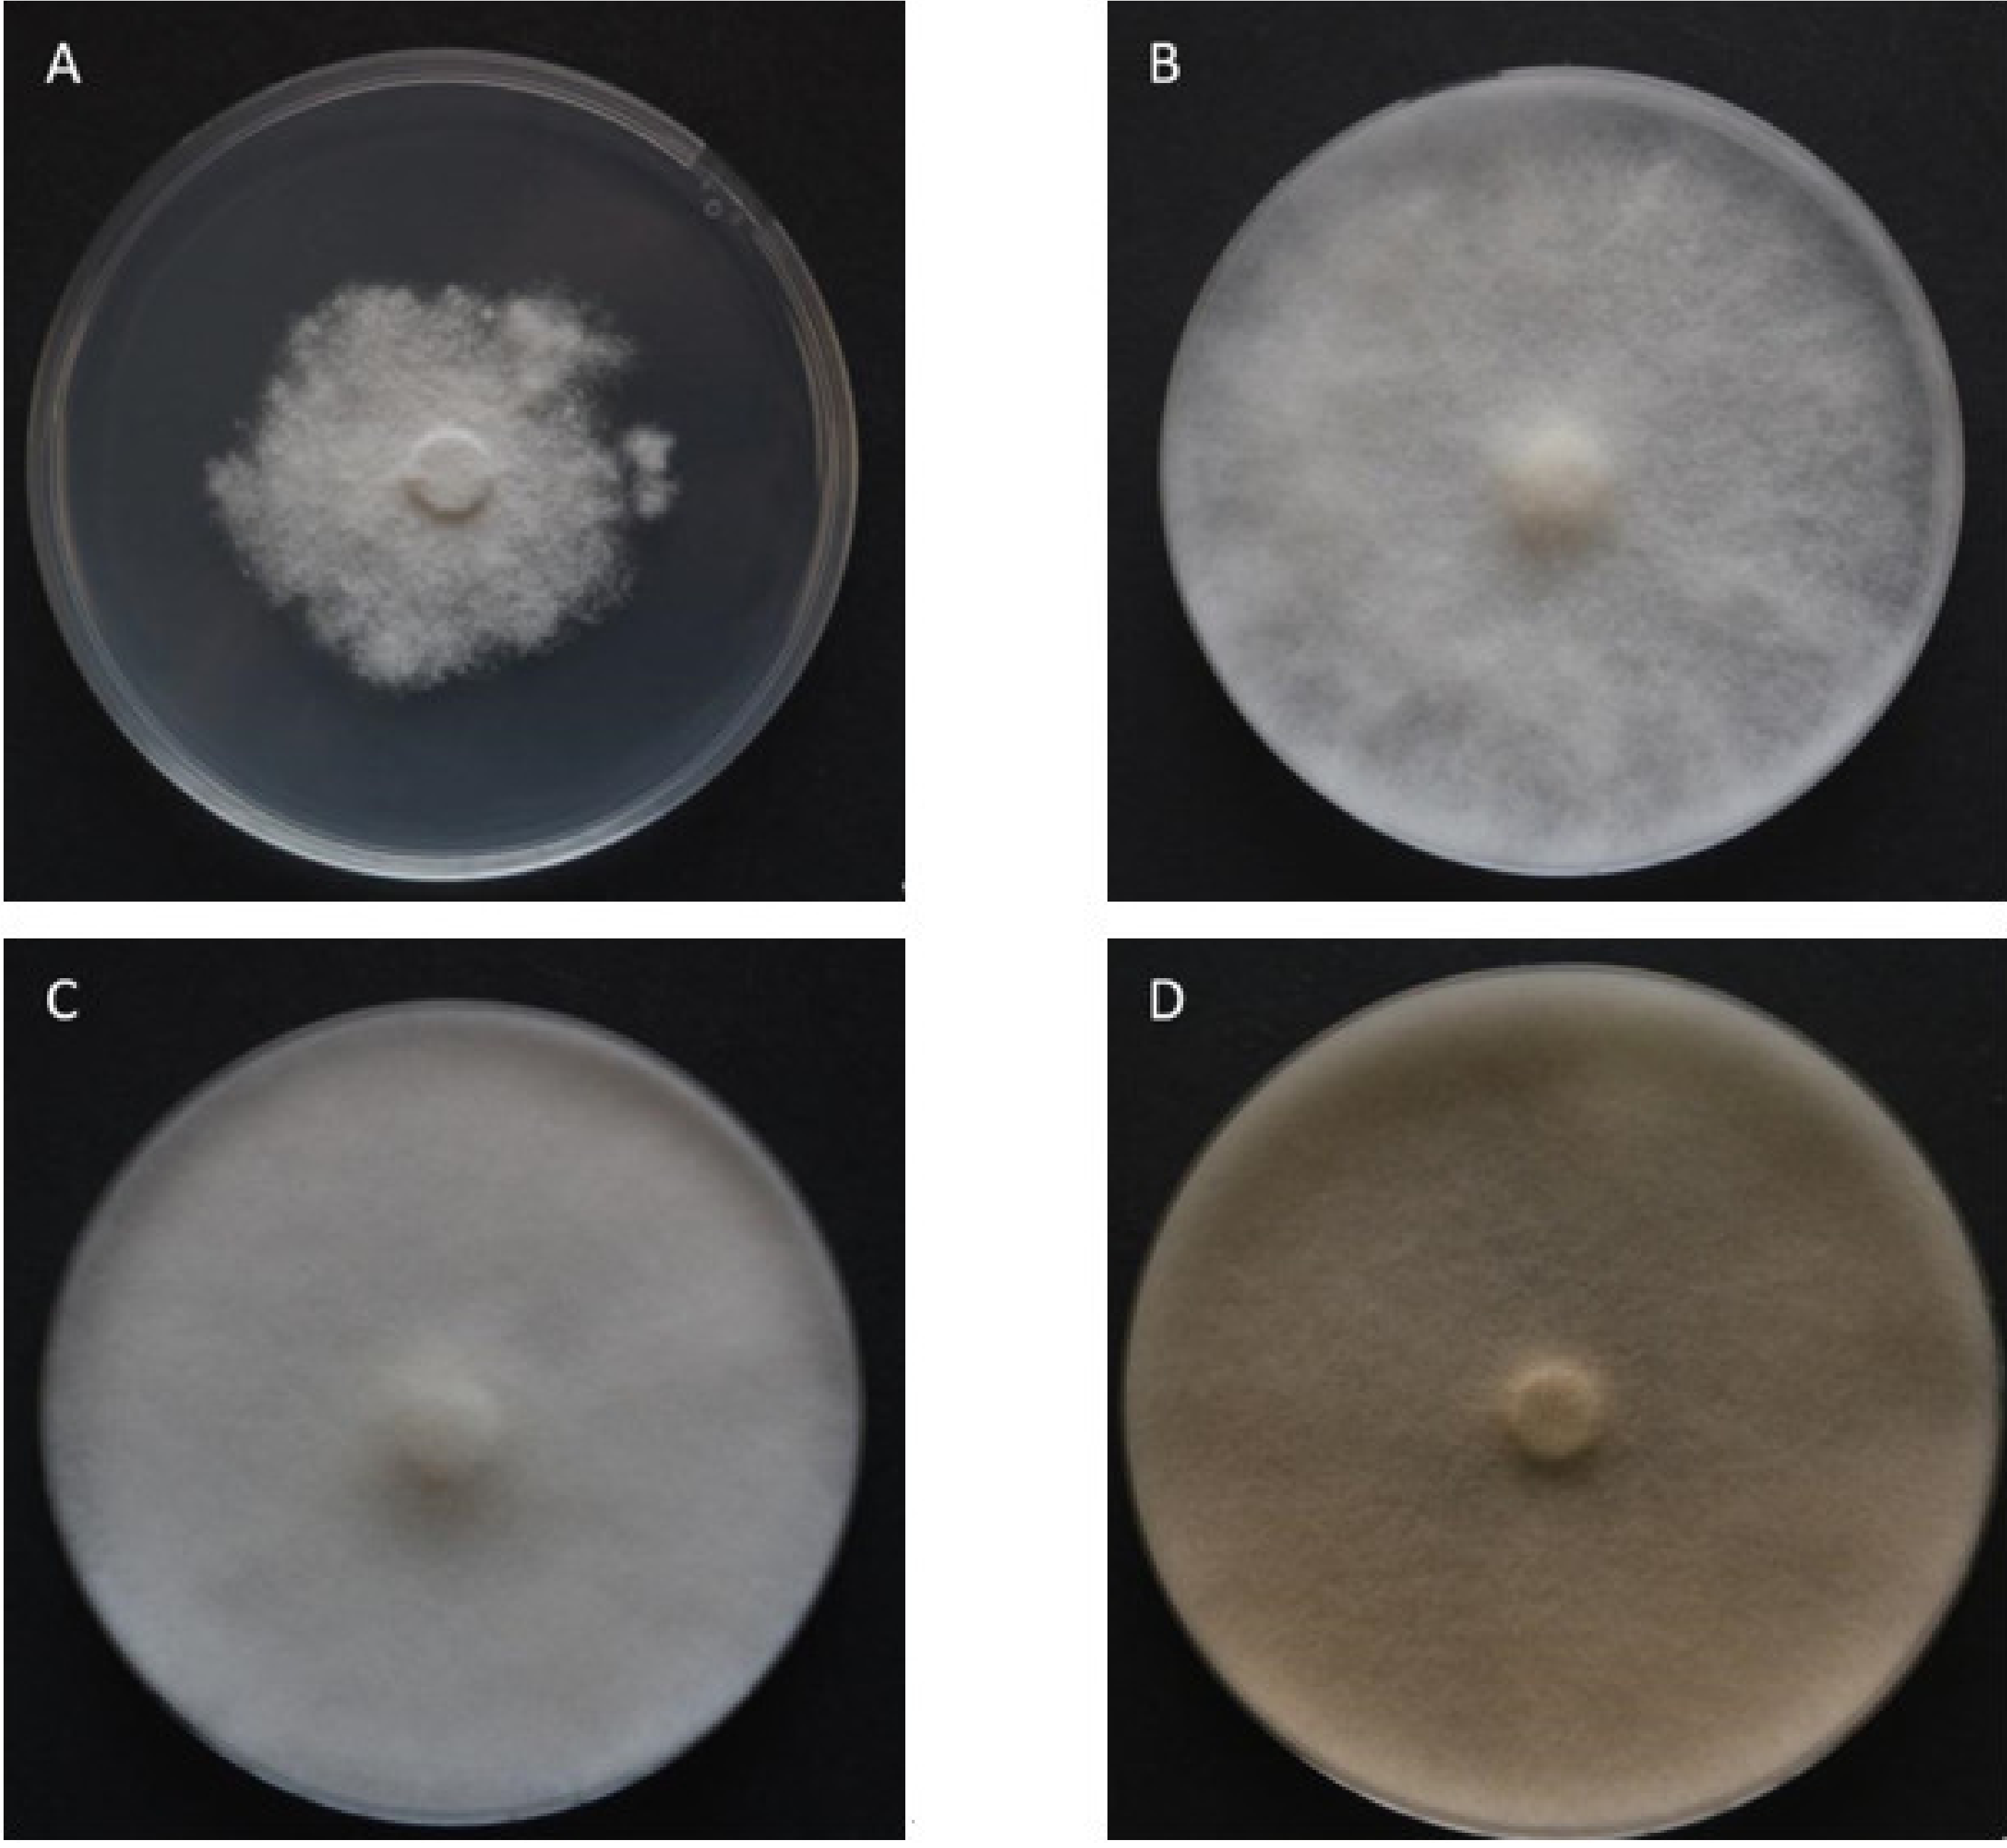
Biology 10 00431 g005

The Effect of Artificial Media and Temperature on the Growth and Development of the Honey Bee Brood Pathogen Ascosphaera apis
Abstract
Simple Summary
Abstract
1. Introduction
2. Materials and Methods
2.1. Fungal Isolate
2.2. Growth Parameters
2.3. Reproductive Structure Production
2.4. Morphometry of Reproductive Structures
2.5. Statistical Analysis
3. Results
3.1. Phylogeny of the ITS Region
3.2. Growth Parameters
3.3. Production of Reproductive Structures
3.3.1. Spore Cysts
3.3.2. Spore Balls
3.3.3. Ascospores
3.4. Morphometry of Reproductive Structures
4. Discussion
4.1. Growth Parameters and Optimal Temperature
4.2. Reproductive Structure Production
4.3. Morphometry of Reproductive Structures
4.4. Strain Competition
5. Conclusions
Author Contributions
Funding
Institutional Review Board Statement
Informed Consent Statement
Data Availability Statement
Conflicts of Interest
Appendix A
| Explanatory Variables | F | Df. | Df. Residual | p-Value |
|---|---|---|---|---|
| Medium | 21.204 | 9 | 180 | <0.001 |
| Temperature | 16.370 | 2 | 180 | <0.001 |
| Mating type | 38.523 | 1 | 180 | <0.001 |
| Medium:Temperature | 0.956 | 18 | 180 | 0.5121 |
| Medium:Mating type | 4.591 | 9 | 180 | <0.001 |
| Temperature:Mating type | 0.096 | 2 | 180 | 0.9082 |
| Medium:Temperature:Mating type | 0.096 | 18 | 180 | 0.9982 |
| Explanatory Variables | Df. | Χ2 | p-Value |
|---|---|---|---|
| Medium | 9 | 374.1 | <0.001 |
| Day | 1 | 6724.2 | <0.001 |
| Mating type | 1 | 290.0 | <0.001 |
| Temperature | 2 | 297.5 | <0.001 |
| Medium:Day | 9 | 81.8 | <0.001 |
| Medium:Mating type | 9 | 423.6 | <0.001 |
| Day:Mating type | 1 | 2.7 | 0.098 |
| Medium:Day:Mating type | 9 | 14.0 | 0.122 |
| Medium | Regression Slopes | Standard Error | p-Value |
|---|---|---|---|
| YGPSA | 2.53 | 0.06857 | <0.001 |
| PDA-BB12 | 2.49 | 0.06282 | <0.001 |
| PDA-BB8 | 2.48 | 0.06392 | <0.001 |
| SDA | 2.47 | 0.06833 | <0.001 |
| PDA-BB4 | 2.45 | 0.05889 | <0.001 |
| MEA | 2.45 | 0.06612 | <0.001 |
| PDAY | 2.36 | 0.06224 | <0.001 |
| PDA | 2.22 | 0.06724 | <0.001 |
| Oxoid ISA | 2.23 | 0.07234 | <0.001 |
| CDA | 1.66 | 0.08585 | <0.001 |
| Explanatory Variables | F | Df. | Df. Residual | p-Value |
|---|---|---|---|---|
| Medium | 314.91 | 5 | 162 | <0.001 |
| Temperature | 1128.41 | 2 | 162 | <0.001 |
| Rep. structures | 1549.62 | 2 | 162 | <0.001 |
| Medium:Temperature | 183.04 | 10 | 162 | <0.001 |
| Medium:Rep. structures | 235.06 | 10 | 162 | <0.001 |
| Temperature:Rep. structures | 1268.48 | 4 | 162 | <0.001 |
| Medium:Temperature:Rep. structures | 124.21 | 20 | 162 | <0.001 |
| Explanatory Variables | F | Df. | Df. Residual | p-Value |
|---|---|---|---|---|
| Medium | 33.7521 | 5 | 228 | <0.001 |
| Temperature | 85.8862 | 2 | 228 | <0.001 |
| Rep. structures | 6794.2763 | 1 | 228 | <0.001 |
| Medium:Temperature | 6.0024 | 10 | 228 | <0.001 |
| Medium:Rep. structures | 24.3856 | 5 | 228 | <0.001 |
| Temperature:Rep. structures | 127.0338 | 2 | 228 | <0.001 |
| Medium:Temperature:Rep. structures | 7.5380 | 10 | 228 | <0.001 |
References
- Gallai, N.; Salles, J.-M.; Settele, J.; Vaissière, B.E. Economic valuation of the vulnerability of world agriculture confronted with pollinator decline. Ecol. Econ. 2009, 68, 810–821. [Google Scholar] [CrossRef]
- Kearns, C.A.; Inouye, D.W.; Waser, N.M. ENDANGERED MUTUALISMS: The Conservation of Plant-Pollinator Interactions. Annu. Rev. Ecol. Syst. 1998, 29, 83–112. [Google Scholar] [CrossRef]
- Klein, A.-M.; Vaissiere, B.E.; Cane, J.H.; Steffan-Dewenter, I.; Cunningham, S.A.; Kremen, C.; Tscharntke, T. Importance of pollinators in changing landscapes for world crops. Proc. R. Soc. B Biol. Sci. 2007, 274, 303–313. [Google Scholar] [CrossRef] [PubMed]
- Aizen, M.A.; Garibaldi, L.A.; Cunningham, S.A.; Klein, A.M. How much does agriculture depend on pollinators? Lessons from long-term trends in crop production. Ann. Bot. 2009, 103, 1579–1588. [Google Scholar] [CrossRef]
- Biesmeijer, J.C.; Roberts, S.P.; Reemer, M.; Ohlemüller, R.; Edwards, M.; Peeters, T.; Schaffers, A.; Potts, S.G.; Kleukers, R.; Thomas, C. Parallel declines in pollinators and insect-pollinated plants in Britain and the Netherlands. Science 2006, 313, 351–354. [Google Scholar] [CrossRef]
- Oldroyd, B.P. What’s killing American honey bees? PLoS Biol. 2007, 5, e168. [Google Scholar] [CrossRef] [PubMed]
- Stokstad, E. The case of the empty hives. Science 2007, 316, 970–972. [Google Scholar] [CrossRef] [PubMed]
- Yoder, J.A.; Jajack, A.J.; Cornacchione, W.S.; Dunn, A.L.; Cunningham, E.G.; Matchett, C.L.; Rosselot, A.E. In vitro evaluation of sugar syrups, antibiotics, and miticides on growth of honey bee pathogen, Ascosphaera apis: Emphasis for chalkbrood prevention is on keeping bees healthy. Apidologie 2014, 45, 568–578. [Google Scholar] [CrossRef]
- Klein, S.; Cabirol, A.; Devaud, J.-M.; Barron, A.B.; Lihoreau, M. Why bees are so vulnerable to environmental stressors. Trends Ecol. Evol. 2017, 32, 268–278. [Google Scholar] [CrossRef] [PubMed]
- Sandrock, C.; Tanadini, M.; Tanadini, L.G.; Fauser-Misslin, A.; Potts, S.G.; Neumann, P. Impact of chronic neonicotinoid exposure on honeybee colony performance and queen supersedure. PLoS ONE 2014, 9, e103592. [Google Scholar] [CrossRef]
- Alaux, C.; Ducloz, F.; Crauser, D.; Le Conte, Y. Diet effects on honeybee immunocompetence. Biol. Lett. 2010, 6, 562–565. [Google Scholar] [CrossRef] [PubMed]
- Hybl, M.; Mraz, P.; Sipos, J.; Pridal, A. Effects of phenolic bioactive substances on reducing mortality of bees (Apis mellifera) intoxicated by thiacloprid. In Proceedings of the MendelNet, Brno, Czech Republic, 6–7 November 2019; pp. 131–135. [Google Scholar]
- Fitzpatrick, Ú.; Murray, T.E.; Paxton, R.J.; Breen, J.; Cotton, D.; Santorum, V.; Brown, M.J. Rarity and decline in bumblebees–a test of causes and correlates in the Irish fauna. Biol. Conserv. 2007, 136, 185–194. [Google Scholar] [CrossRef]
- Ansari, M.J.; Al-Ghamdi, A.; Usmani, S.; Khan, K.A.; Alqarni, A.S.; Kaur, M.; Al-Waili, N. In vitro evaluation of the effects of some plant essential oils on Ascosphaera apis, the causative agent of Chalkbrood disease. Saudi J. Biol. Sci. 2017, 24, 1001–1006. [Google Scholar] [CrossRef] [PubMed]
- Higes, M.; Martín-Hernández, R.; Garrido-Bailón, E.; González-Porto, A.V.; García-Palencia, P.; Meana, A.; Del Nozal, M.J.; Mayo, R.; Bernal, J.L. Honeybee colony collapse due to Nosema ceranae in professional apiaries. Environ. Microbiol. Rep. 2009, 1, 110–113. [Google Scholar] [CrossRef] [PubMed]
- Spiltoir, C.F. Life cycle of Ascosphaera apis (Pericystis apis). Am. J. Bot. 1955, 42, 501–508. [Google Scholar] [CrossRef]
- Strasser, H. Use of hyphomycetous fungi for managing insect pests. In Fungi as Biocontrol Agents: Progress Problems and Potential; CABI: Wallingford, UK, 2001; p. 23. [Google Scholar]
- Mannino, M.C.; Huarte-Bonnet, C.; Davyt-Colo, B.; Pedrini, N. Is the insect cuticle the only entry gate for fungal infection? Insights into alternative modes of action of entomopathogenic fungi. J. Fungi 2019, 5, 33. [Google Scholar] [CrossRef]
- James, T.Y.; Kauff, F.; Schoch, C.L.; Matheny, P.B.; Hofstetter, V.; Cox, C.J.; Celio, G.; Gueidan, C.; Fraker, E.; Miadlikowska, J. Reconstructing the early evolution of Fungi using a six-gene phylogeny. Nature 2006, 443, 818–822. [Google Scholar] [CrossRef] [PubMed]
- Heath, L.; Gaze, B.M. Carbon dioxide activation of spores of the chalkbrood fungus Ascosphaera apis. J. Apic. Res. 1987, 26, 243–246. [Google Scholar] [CrossRef]
- Bailey, L. The effect of temperature on the pathogenicity of the fungus, Ascosphaera apis, for larvae of the honey bee, Apis mellifera. Insect Pathol. Microb. Control 1966, 162–167. [Google Scholar]
- Aronstein, K.A.; Murray, K.D. Chalkbrood disease in honey bees. J. Invertebr. Pathol. 2010, 103, S20–S29. [Google Scholar] [CrossRef] [PubMed]
- Li, Z.; You, X.-L.; Wang, L.-L.; Yan, Z.-T.; Zhou, Z.-Y. Spore morphology and ultrastructure of an Ascosphaera apis strain from the honeybees (Apis mellifera) in southwest China. Mycologia 2018, 110, 325–338. [Google Scholar] [CrossRef] [PubMed]
- Liu, T.; Peng, C.; Mussen, E.; Marston, J.; Munn, R. Ultrastructure of the freeze-etched spore of Ascosphaera apis, an entomopathogenic fungus of the honeybee Apis mellifera. J. Invertebr. Pathol. 1991, 57, 371–379. [Google Scholar] [CrossRef]
- Bamford, S.; Heath, L. The effects of temperature and pH on the germination of spores of the chalkbrood fungus, Ascosphaera apis. J. Apic. Res. 1989, 28, 36–40. [Google Scholar] [CrossRef]
- Jensen, A.B.; Aronstein, K.; Flores, J.M.; Vojvodic, S.; Palacio, M.A.; Spivak, M. Standard methods for fungal brood disease research. J. Apic. Res. 2013, 52, 1–20. [Google Scholar] [CrossRef] [PubMed]
- Evison, S.E. Chalkbrood: Epidemiological perspectives from the host–parasite relationship. Curr. Opin. Insect Sci. 2015, 10, 65–70. [Google Scholar] [CrossRef] [PubMed]
- Heath, L. Development of chalk brood in a honeybee colony: A review. Bee World 1982, 63, 119–130. [Google Scholar] [CrossRef]
- De Jong, D. Experimental enhancement of chalk brood infections. Bee World 1976, 57, 114–115. [Google Scholar] [CrossRef]
- Hedtke, K.; Jensen, P.M.; Jensen, A.B.; Genersch, E. Evidence for emerging parasites and pathogens influencing outbreaks of stress-related diseases like chalkbrood. J. Invertebr. Pathol. 2011, 108, 167–173. [Google Scholar] [CrossRef]
- Vojvodic, S.; Jensen, A.B.; James, R.R.; Boomsma, J.J.; Eilenberg, J. Temperature dependent virulence of obligate and facultative fungal pathogens of honeybee brood. Vet. Microbiol. 2010, 149, 200–205. [Google Scholar] [CrossRef] [PubMed]
- Dallman, H. Neue Wege bei der Bekämpfung der Kalkbrut in Bienenenvölkern. Merkbl. Imker Verb. KleingärtnerSiedl. Klein-Tierzüchter 1974, 8, 1–36. [Google Scholar]
- Dreher, K. Auftreten von Bienenkrankheiten in Niedersachsen und Braunschweig im Jahre 1937. Niedersachs. Imker 1938, 73, 282–284. [Google Scholar]
- Roussy, L. Nouvelle contribution à l’étude du Per-icystis apis. Gaz Apic 1962, 63, 101–105. [Google Scholar]
- Cooper, B. Fluctuating broodnest temperature rhythm. Br. Isles Bee Breed. News 1980, 18, 1216. [Google Scholar]
- Tabarly, O.; Monteira, E. Influence de la teneur en eau du miel sur le développement des mycoses. Bull Apic. 1961, 4, 31–34. [Google Scholar]
- Flores, J.; Ruiz, J.; Ruz, J.; Puerta, F.; Bustos, M.; Padilla, F.; Campano, F. Effect of temperature and humidity of sealed brood on chalkbrood development under controlled conditions. Apidologie 1996, 27, 185–192. [Google Scholar] [CrossRef]
- Koenig, J.; Boush, G.M.; Erickson, E., Jr. Effects of spore introduction and ratio of adult bees to brood on chalkbrood disease in honeybee colonies. J. Apic. Res. 1987, 26, 191–195. [Google Scholar] [CrossRef]
- Chantawannakul, P.; Puchanichanthranon, T.; Wongsiri, S. Inhibitory effects of some medicinal plant extracts on the growth of Ascosphaera apis. In III WOCMAP Congress on Medicinal and Aromatic Plants—Volume 4: Targeted Screening of Medicinal and Aromatic Plants, Economics 678; ISHS: Chiang Mai, Thailand, 2005; pp. 183–189. [Google Scholar]
- Chen, D.; Guo, R.; Xiong, C.; Zheng, Y.; Hou, C.; Fu, Z. Morphological and molecular identification of chalkbrood disease pathogen Ascosphaera apis in Apis cerana cerana. J. Apic. Res. 2018, 57, 516–521. [Google Scholar] [CrossRef]
- Zaghloul, O.; Mourad, A.; El Kady, M.B.; Nemat, F.; Morsy, M. Assessment of losses in honey yield due to the chalkbrood disease, with reference to the determination of its economic injury levels in Egypt. Commun. Agric. Appl. Biol. Sci. 2005, 70, 703–714. [Google Scholar]
- Guo, R.; Chen, D.; Xiong, C.; Hou, C.; Zheng, Y.; Fu, Z.; Diao, Q.; Zhang, L.; Wang, H.; Hou, Z. Identification of long non-coding RNAs in the chalkbrood disease pathogen Ascospheara apis. J. Invertebr. Pathol. 2018, 156, 1–5. [Google Scholar] [CrossRef]
- Gilliam, M.; Taber, S., III; Richardson, G.V. Hygienic behavior of honey bees in relation to chalkbrood disease. Apidologie 1983, 14, 29–39. [Google Scholar] [CrossRef]
- Chaimanee, V.; Thongtue, U.; Sornmai, N.; Songsri, S.; Pettis, J.S. Antimicrobial activity of plant extracts against the honeybee pathogens, Paenibacillus larvae and Ascosphaera apis and their topical toxicity to Apis mellifera adults. J. Appl. Microbiol. 2017, 123, 1160–1167. [Google Scholar] [CrossRef]
- Mraz, P.; Bohata, A.; Hostickova, I.; Kopecky, M.; Zabka, M.; Hybl, M.; Curn, V. Inhibitory effect of selected botanical compounds on the honey bee fungal pathogen Ascosphaera apis. In Proceedings of the MendelNet, Brno, Czech Republic, 6–7 November 2019; pp. 474–479. [Google Scholar]
- Vega, F.E.; Goettel, M.S.; Blackwell, M.; Chandler, D.; Jackson, M.A.; Keller, S.; Koike, M.; Maniania, N.K.; Monzon, A.; Ownley, B.H. Fungal entomopathogens: New insights on their ecology. Fungal Ecol. 2009, 2, 149–159. [Google Scholar] [CrossRef]
- Ibrahim, L.; Butt, T.M.; Jenkinson, P. Effect of artificial culture media on germination, growth, virulence and surface properties of the entomopathogenic hyphomycete Metarhizium anisopliae. Mycol. Res. 2002, 106, 705–715. [Google Scholar] [CrossRef]
- Liu, F.; Wu, X.; He, Z.; Xiang, M.; He, Y.; Liu, X.; Chen, S.; Zeng, W. Nutritional effects on the mycelial growth and enzymatic activity of Isaria farinosa, and Hepialus larvae growth. J. Appl. Microbiol. 2016, 120, 1605–1615. [Google Scholar] [CrossRef] [PubMed]
- Wyss, G.S.; Charudattan, R.; DeValerio, J.T. Evaluation of agar and grain media for mass production of conidia of Dactylaria higginsii. Plant Dis. 2001, 85, 1165–1170. [Google Scholar] [CrossRef] [PubMed]
- Safavi, S.; Shah, F.A.; Pakdel, A.K.; Reza Rasoulian, G.; Bandani, A.R.; Butt, T.M. Effect of nutrition on growth and virulence of the entomopathogenic fungus Beauveria bassiana. FEMS Microbiol. Lett. 2007, 270, 116–123. [Google Scholar] [CrossRef] [PubMed]
- Garrido-Bailón, E.; Higes, M.; Martínez-Salvador, A.; Antúnez, K.; Botías, C.; Meana, A.; Prieto, L.; Martín-Hernández, R. The prevalence of the honeybee brood pathogens Ascosphaera apis, Paenibacillus larvae and Melissococcus plutonius in S panish apiaries determined with a new multiplex PCR assay. Microb. Biotechnol. 2013, 6, 731–739. [Google Scholar] [CrossRef] [PubMed]
- Altschul, S.F.; Gish, W.; Miller, W.; Myers, E.W.; Lipman, D.J. Basic local alignment search tool. J. Mol. Biol. 1990, 215, 403–410. [Google Scholar] [CrossRef]
- Sayers, E.W.; Barrett, T.; Benson, D.A.; Bolton, E.; Bryant, S.H.; Canese, K.; Chetvernin, V.; Church, D.M.; DiCuccio, M.; Federhen, S. Database resources of the national center for biotechnology information. Nucleic Acids Res. 2010, 39, D38–D51. [Google Scholar] [CrossRef] [PubMed]
- Wobbrock, J.O.; Findlater, L.; Gergle, D.; Higgins, J.J. The aligned rank transform for nonparametric factorial analyses using only anova procedures. In Proceedings of the SIGCHI Conference on Human Factors in Computing Systems, Vancouver, BC, Canada, 7–12 May 2011; pp. 143–146. [Google Scholar]
- Mansouri, H. Multifactor analysis of variance based on the aligned rank transform technique. Comput. Stat. Data Anal. 1998, 29, 177–189. [Google Scholar] [CrossRef]
- Lenth, R.; Singmann, H.; Love, J.; Buerkner, P.; Herve, M. Emmeans: Estimated marginal means, aka least-squares means. R Package Version 2018, 1, 3. [Google Scholar]
- Yan, J.; Fine, J. Estimating equations for association structures. Stat. Med. 2004, 23, 859–874. [Google Scholar] [CrossRef] [PubMed]
- Heath, L. Chalk brood pathogens: A review. Bee World 1982, 63, 130–135. [Google Scholar] [CrossRef]
- Huber, J. Untersuchungen zur Physiologie insektentötender Pilze. Arch. Für Mikrobiol. 1958, 29, 257–276. [Google Scholar] [CrossRef]
- Medrzycki, P.; Sgolastra, F.; Bortolotti, L.; Bogo, G.; Tosi, S.; Padovani, E.; Porrini, C.; Sabatini, A.G. Influence of brood rearing temperature on honey bee development and susceptibility to poisoning by pesticides. J. Apic. Res. 2010, 49, 52–59. [Google Scholar] [CrossRef]
- Wang, Q.; Xu, X.; Zhu, X.; Chen, L.; Zhou, S.; Huang, Z.Y.; Zhou, B. Low-temperature stress during capped brood stage increases pupal mortality, misorientation and adult mortality in honey bees. PLoS ONE 2016, 11, e0154547. [Google Scholar] [CrossRef] [PubMed]
- Anderson, D.L.; Gibson, N.L. New species and isolates of spore-cyst fungi (Plectomycetes: Ascosphaerales) from Australia. Aust. Syst. Bot. 1998, 11, 53–72. [Google Scholar] [CrossRef]
- Maurizio, A. Beiträge zur Kenntnis der Pilzflora im Bienenstock: Die Pericystit-Infektion der Bienenlarven. Ber. Schweiz. Bot. Ges. 1935, 44, 133–156. [Google Scholar]
- Bissett, J. Contribution toward a monograph of the genus Ascosphaera. Can. J. Bot. 1988, 66, 2541–2560. [Google Scholar] [CrossRef]
- Eble, H.; Weide, W. Die Bekämpfung von Pericystis apis Maassen in Labor und Praxis. Wiss. Z. Univ. HalleMath. Nat. Riehe 1961, 10, 83–86. [Google Scholar]
- Claussen, P. Entwicklungsgeschichtliche Untersuchungen über den Erreger der als” Kalkbrut” bezeichneten Krankheit der Bienen; Parey: Berlin, Germany, 1921. [Google Scholar]
- Evison, S.; Foley, K.; Jensen, A.; Hughes, W. Genetic diversity, virulence and fitness evolution in an obligate fungal parasite of bees. J. Evol. Biol. 2015, 28, 179–188. [Google Scholar] [CrossRef] [PubMed]
- Damialis, A.; Mohammad, A.B.; Halley, J.M.; Gange, A.C. Fungi in a changing world: Growth rates will be elevated, but spore production may decrease in future climates. Int. J. Biometeorol. 2015, 59, 1157–1167. [Google Scholar] [CrossRef] [PubMed]
- Ruffinengo, S.; Peña, N.; Clemente, G.; Palacio, M.; Escande, A. Suitability of culture media for the production of ascospores and maintenance of Ascosphaera apis. J. Apic. Res. 2000, 39, 143–148. [Google Scholar] [CrossRef]
- Flores, J.; Spivak, M.; Gutiérrez, I. Spores of Ascosphaera apis contained in wax foundation can infect honeybee brood. Vet. Microbiol. 2005, 108, 141–144. [Google Scholar] [CrossRef]
- Gochnauer, T.; Margetts, V. Decontaminating effect of ethylene oxide on honeybee larvae previously killed by chalk-brood disease. J. Apic. Res. 1980, 19, 261–264. [Google Scholar] [CrossRef]
- Reynaldi, F.J.; Lucia, M.; Garcia, M.L.G. Ascosphaera apis, the entomopathogenic fungus affecting larvae of native bees (Xylocopa augusti): First report in South America. Rev. Iberoam. Micol. 2015, 32, 261–264. [Google Scholar] [CrossRef] [PubMed]
- Chorbinski, P.; Rypula, K. Studies on the morphology of strains Ascosphaera apis isolated from chalkbrood disease of the honey bees. Electron. J. Pol. Agric. Univ. 2003, 6, 1–12. [Google Scholar]
- Frank, S.A. Models of parasite virulence. Q. Rev. Biol. 1996, 71, 37–78. [Google Scholar] [CrossRef] [PubMed]
- Gilliam, M.; Lorenz, B.; Wenner, A.; Thorp, R. Occurrence and distribution of Ascosphaera apis in North America: Chalkbrood in feral honey bee colonies that had been in isolation on Santa Cruz Island, California for over 110 years. Apidologie 1997, 28, 329–338. [Google Scholar] [CrossRef][Green Version]
- Alizon, S.; de Roode, J.C.; Michalakis, Y. Multiple infections and the evolution of virulence. Ecol. Lett. 2013, 16, 556–567. [Google Scholar] [CrossRef]
- Alizon, S.; Hurford, A.; Mideo, N.; Van Baalen, M. Virulence evolution and the trade-off hypothesis: History, current state of affairs and the future. J. Evol. Biol. 2009, 22, 245–259. [Google Scholar] [CrossRef]
- Klinger, E.G.; Vojvodic, S.; DeGrandi-Hoffman, G.; Welker, D.L.; James, R.R. Mixed infections reveal virulence differences between host-specific bee pathogens. J. Invertebr. Pathol. 2015, 129, 28–35. [Google Scholar] [CrossRef] [PubMed]
- Brown, S.P.; Hochberg, M.E.; Grenfell, B.T. Does multiple infection select for raised virulence? Trends Microbiol. 2002, 10, 401–405. [Google Scholar] [CrossRef]
- Buckling, A.; Brockhurst, M. Kin selection and the evolution of virulence. Heredity 2008, 100, 484–488. [Google Scholar] [CrossRef] [PubMed]
- Gilliam, M. Infectivity and survival of the chalkbrood pathogen, Ascosphaera apis, in colonies of honey bees, Apis mellifera. Apidologie 1986, 17, 93–100. [Google Scholar] [CrossRef]

Publisher’s Note: MDPI stays neutral with regard to jurisdictional claims in published maps and institutional affiliations. |
© 2021 by the authors. Licensee MDPI, Basel, Switzerland. This article is an open access article distributed under the terms and conditions of the Creative Commons Attribution (CC BY) license (https://creativecommons.org/licenses/by/4.0/).
Share and Cite
Mráz, P.; Hýbl, M.; Kopecký, M.; Bohatá, A.; Konopická, J.; Hoštičková, I.; Konvalina, P.; Šipoš, J.; Rost, M.; Čurn, V. The Effect of Artificial Media and Temperature on the Growth and Development of the Honey Bee Brood Pathogen Ascosphaera apis. Biology 2021, 10, 431. https://doi.org/10.3390/biology10050431
Mráz P, Hýbl M, Kopecký M, Bohatá A, Konopická J, Hoštičková I, Konvalina P, Šipoš J, Rost M, Čurn V. The Effect of Artificial Media and Temperature on the Growth and Development of the Honey Bee Brood Pathogen Ascosphaera apis. Biology. 2021; 10(5):431. https://doi.org/10.3390/biology10050431
Chicago/Turabian StyleMráz, Petr, Marian Hýbl, Marek Kopecký, Andrea Bohatá, Jana Konopická, Irena Hoštičková, Petr Konvalina, Jan Šipoš, Michael Rost, and Vladislav Čurn. 2021. "The Effect of Artificial Media and Temperature on the Growth and Development of the Honey Bee Brood Pathogen Ascosphaera apis" Biology 10, no. 5: 431. https://doi.org/10.3390/biology10050431
APA StyleMráz, P., Hýbl, M., Kopecký, M., Bohatá, A., Konopická, J., Hoštičková, I., Konvalina, P., Šipoš, J., Rost, M., & Čurn, V. (2021). The Effect of Artificial Media and Temperature on the Growth and Development of the Honey Bee Brood Pathogen Ascosphaera apis. Biology, 10(5), 431. https://doi.org/10.3390/biology10050431







